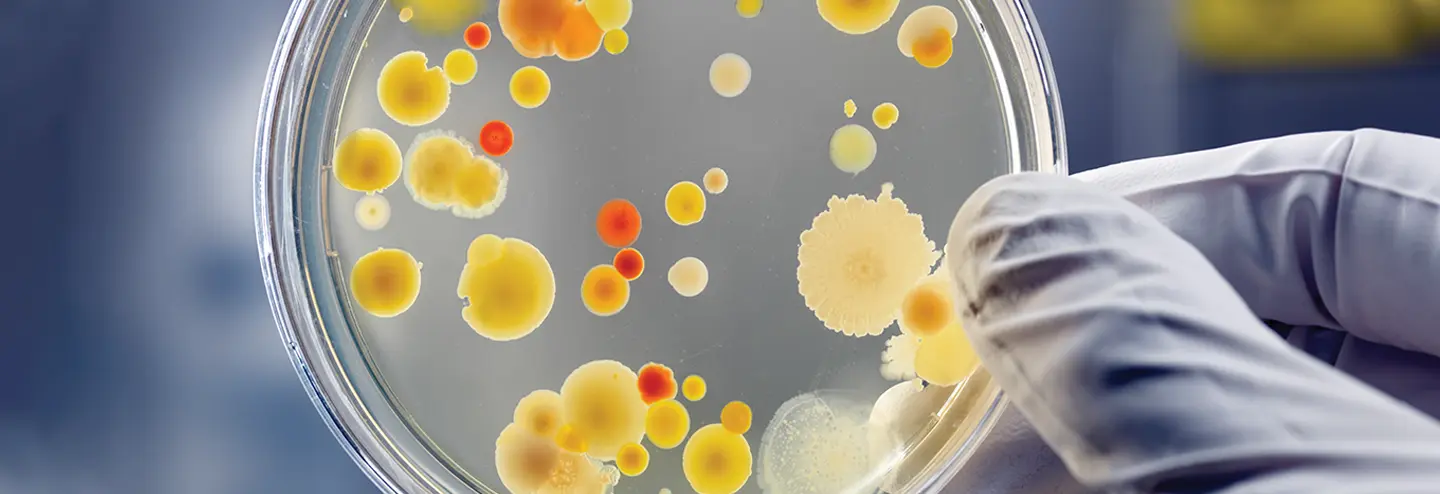
Supporting AAV and Lentiviral Vector Development and Commercialization

Biotech / Biosimilars

Fab Biopharma
Revolutionizing Biologics (and Biology) through a Focus on Women


Cell Therapy

Cell X Technologies
Facilitating Organoid Production for Biopharmaceutical Applications


Lab Equipment

Alpenglow Biosciences
Accelerating Drug Development with AI-Enabled 3D Spatial Biology